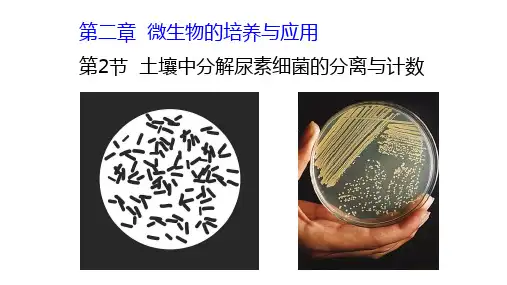

土壤中分解尿素细菌的分离和计数
- 格式:ppt
- 大小:409.00 KB
- 文档页数:27

“土壤中分解尿素的细菌的分离与计数”的教学设计与实施1教材分析与课时安排“土壤中分解尿素的细菌的分离与计数”是人教版高中生物(选修1)专题2“微生物的培养与应用”的第二个课题,学生已学习了有关培养基和无菌技术的基本知识,在掌握使用平板划线法和稀释涂布法、分离和纯化微生物的实验操作的基础上,研究培养基对微生物的选择作用,并测定其数量。
其中既有关于特定菌株的选择策略等知识性内容,又有土壤溶液的稀释、菌落数量统计等操作性内容,难度较大、探究性较强,是培养学生设计实验、动手操作等科学探究能力,提高生物科学素养的好素材。
本课题教学实施中的关键在于两点:①教师要处理好知识性内容与操作性内容的关系,要让学生理解特定菌株的选择策略,并学习有关的实验方法和操作程序;②处理好课常与课后的关系。
本课题的实验操作时间不长,但是操作前要制备培养基、对培养基和其他操作用具进行灭菌,操作后的培养时间和对微生物进行观察则需要较长时间,因此需要教师精心设计教学程序,统筹安排教学时间。
根据这一教材特点,本课题教学可分2个课时进行,2个课时之间应留有2 d左右的间隔,以便进行微生物的培养与观察。
2教学目标2.1知识目标简述稀释涂布平板法分离微生物和进行微生物计数的实验原理;说出选择性培养基和鉴别性培养基的用途;归纳分离纯化微生物的原理和方法。
2.2能力目标学会制备土壤样本稀释液,学会用稀释涂布法将菌样液接种到固体培养基平板;学会用稀释涂布平板法进行微生物数量测定的方法。
2.3情感、态度与价值观目标体验科学知识的形成过程,加深对科学本质的理解;体会在实验活动中合作学习的有效性,养成严谨的科学态度。
3教学准备3.1土壤样品的采集以及土壤溶液的配制为保证实验取得预期效果,应选择经常施用尿素的农田,铲去表土后采集3~8 cm深度范围内的土壤;回实验室后,去除土壤中的植物枯枝败叶及其他杂物,用托盘天平称取样品10 g,加入到盛有90g无菌水的锥形瓶中,震荡10min,即制得101土壤溶液;制备完成后可置于冰箱冷藏室内备用(1~2 d)。

土壤中分解尿素的细菌的分离与计数(1)一、研究背景和意义土壤中的细菌群落对于土壤生态系统的基本功能起着至关重要的作用。
其中,土壤微生物的代表——细菌在土壤有机质的分解中是不可或缺的,其中包括尿素的分解。
尿素是一种有机氮化合物,很多植物都会把尿素当作氮素的主要来源。
但是,尿素很容易被细菌分解成为氨气,因此,如果过量的尿素进入土壤,细菌可能会分解尿素而产生氨气,而氨气毒性较强,可能对于周围的生态产生较大的负面影响。
因此,研究土壤中分解尿素的细菌的分离与计数,有助于深入了解尿素分解的生态机理,从而为保护土壤生态环境提供理论基础和技术支持。
二、实验目的1.利用培养基筛选土壤中分解尿素的细菌,并分离单种菌株。
2.利用计数法确定土壤中分解尿素的细菌群落的数量。
3.了解土壤中分解尿素的细菌群落的形态特征和特点。
三、实验步骤1.尿素培养基制备:将1000ml蒸馏水与20g尿素、0.5g葡萄糖、0.1g磷酸氢二钾、0.2g酵母提取物、0.1g镁硫酸钾、0.5g氯化钠、0.5g硫酸铵、15g琼脂、适量pH指示剂溶解在一起,灭菌后即可得到尿素培养基。
2.样品制备:取10g土壤样品加入稀溶液后混合均匀,再经过过滤器过滤掉大颗粒,得到土壤浸液样品。
3.单种菌株筛选:将土壤浸液样品接种到尿素培养基中,在28℃下培养2-3天。
筛选到单种菌株后,通过高倍显微镜观察菌落的形态和特点,然后进行相应的鉴定。
4.计数法:将稀溶液进行逐步稀释,然后取稀释液的适量体积接种在尿素培养基上,在28℃下培养2-3天,根据菌落数确定土壤中细菌的数量。
四、实验结果及分析通过尿素培养基的筛选,共分离出5种分解尿素的细菌,并进行了表征与鉴定。
通过计数法,成功地计算出了土壤中的分解尿素的细菌数量。
土壤中分解尿素的细菌群落种类多样,数量较多,这对于土壤中尿素分解的生态机理研究具有重要的意义。
同时,该实验的操作简单,成本低廉,适用于在实验室环境下大规模进行。

土壤中分解尿素的细菌的分离与计数1、如图为“土壤中分解尿素的细菌的分离和计数”实验中样品稀释示意图。
据图分析正确的是( )A.3号试管的稀释倍数为103倍B.5号试管的结果表明每克土壤中的菌株数为1.7×109个C.5号试管中稀释液进行平板培养得到的菌落平均数恰为4号试管的10倍D.该方法和平板划线法都可对微生物进行准确计数2、下列能选择出分解尿素的细菌的培养基是( )A. KH2PO4、Na2HPO4、MgSO4.7H2O、葡萄糖、尿素、琼脂、水B. KH2PO4、Na2HPO4、MgSO4.7H2O、葡萄糖、琼脂、水C. KH2PO4、Na2HPO4、MgSO4.7H2O、尿素、琼脂、水D. KH2PO4、Na2HPO4、MgSO4.7H2O、牛肉膏、蛋白胨、琼脂、水3、如图为“土壤中分解尿素的细菌的分离和计数”实验示意图。
据图分析下列叙述正确的是( )A.3号试管中样品的稀释倍数为103倍B.用4号试管中稀释液进行平板培养得到的菌落平均数约为5号试管的10倍C.5号试管的结果表明每克土壤中的菌株数为1.7×108个D.该实验方法统计得到的结果往往会比实际活菌数目要高4、如图为纤维单胞菌(能产生纤维素酶)的获取过程。
下列有关叙述错误的是( )A.①②③④培养基都应以纤维素为唯一碳源B.图中所用培养基灭菌常用的方法是高压蒸汽灭菌法C.④所用的接种方法可对培养的微生物进行计数D.可用刚果红染料鉴定,看菌落周围是否出现透明圈5、某同学要分离土壤中能分解尿素的细菌,并统计每克土壤样品中活菌数目,培养基配方如下。
将各种物质溶解后,用蒸馏水定容到1 000 mL,再经高温灭菌,制成固体培养基备用。
(1)),原因是________________________________。
(2)培养基常用________法灭菌,培养皿常用________法灭菌,待培养基冷却到________(填“20”、“30”、“40”或“50”) ℃左右时,在________附近倒平板,等平板冷却凝固后,将平板倒过来放置,可以防止________________,造成污染。

【土壤中分解尿素的细菌的分离和计数】一、研究思路1.筛选菌株尿素是一种重要的肥,农作物不能直接吸收利用,而是首先通过土壤中的细菌将尿素分解为和CO2,才能被植物利用,土壤中的这些细菌之所以能分解尿素,是因为它们能合成。
可以利用这一特点,将其从土壤中筛选出来。
(1)实验室中微生物筛选的原理:人为提供有利于_____ _生长的条件(包括营养、、pH等),同时____ _或其他微生物生长。
(2)选择培养基:在微生物学中,将允许的微生物生长,同时和其他种类微生物生长的培养基,称作选择培养基。
2.统计菌落数目(1)常用来统计样品中数目的方法是__________ _______。
即当样品的稀释度足够高时,培养基表面生长的一个菌落,来源于样品稀释液中。
通过统计平板上的,就能推测出样品中大约含有多少活菌。
为了保证结果准确,一般选择菌落数在的平板进行计数。
例如每克样品中的菌株数= ,C代表 ,V代表 ,M代表。
通常统计出的菌落数比活菌的实际数目。
这是因为。
因此,统计结果一般用而不是活菌数来表示。
(2) 也是测定微生物数量的常用方法。
(3)细菌的数目还可以通过法来测定。
例如,测定饮水中大肠杆菌的数量,可将的水用细菌过滤器过滤后,将滤膜放到培养基上培养,大肠杆菌菌落呈现色,可以根据培养基上的数目,计算出水样中大肠杆菌的数量。
在该实验中至少应取___个水样。
3.设置对照(1)设置对照的主要目的是排除实验组中___________对实验结果的影响,提高实验结果的。
例如为了排除培养基是否被杂菌污染了,需用______________________________ 作为空白对照。
(2)对照实验是指除了的条件外,其他条件都的实验,其作用是比照实验组,排除任何其他可能原因的干扰,证明确实是所测试的条件引起相应的结果。
二、实验设计实验设计包括对实验方案,所需仪器、材料,用具和药品,具体的以及时间安排等的综合考虑和安排。
关于土壤中某样品细菌的分离与计数的实验操作步骤如下:1.土壤取样土壤微生物约70%~80%为,主要分布在距地表的近性土壤中。



《土壤中分解尿素的细菌的分离与计数》教学设计方案(第一课时)一、教学目标:1. 掌握土壤中分解尿素的细菌的分离和计数方法;2. 了解细菌的分类和作用;3. 培养实验操作技能和科学探究精神。
二、教学重难点:1. 教学重点:掌握细菌分离和计数的实验方法;2. 教学难点:实验中可能出现的问题及解决方法,培养周密的科学态度。
三、教学准备:1. 实验用器械:无菌土壤、无菌水、稀释液、涂布器、显微镜、计数板等;2. 实验用试剂和培养基:尿素、琼脂培养基、抗生素等;3. 教师准备教学PPT,介绍细菌分类、作用以及尿素分解菌的介绍;4. 预先设计好实验表格,方便学生记录数据。
课时安排:共2课时,本设计为第一课时。
四、教学过程:1. 导入新课向学生介绍本节课的目标和意义,讲解尿素分解菌在农业、工业和医药等领域的应用,激发学生的兴趣和求知欲。
2. 实验原理讲解向学生介绍实验的背景、目标、方法、步骤和实验原理,包括选择培养基的制备、分离尿素的指示剂的配制、细菌的接种和培养等。
3. 实验操作示范教师进行实验操作示范,包括无菌操作、接种、培养等步骤,并强调实验中的注意事项,如无菌操作、菌落的识别等。
4. 学生分组实验将学生分成若干小组,每组分别进行实验操作,并记录实验结果。
教师巡视指导,纠正学生的错误操作,确保实验的顺利进行。
5. 结果分析与讨论学生根据实验结果进行讨论,分析哪些菌落可能是分解尿素的细菌,并尝试诠释分离到的细菌数量差别的原因。
教师对学生的讨论进行点评和指导,帮助学生更好地理解实验结果和实验原理。
6. 知识拓展介绍土壤中其他类型的细菌及其作用,如分解纤维素的细菌、分解脂肪的细菌等,以及它们在农业、工业和医药领域的应用。
同时,引导学生思考如何利用这些细菌来改善土壤质量、提高农作物的产量和品质。
7. 课后作业与反思要求学生回顾本节课的内容,完成相关作业,思考自己在实验操作和结果分析中存在的问题,并在今后的学习中加以改进。

专题03土壤中分解尿素的细菌的分离与计数一、实验原理:(1)土壤中的细菌之所以能分解尿素是因为它们能合成尿酶。
(2)配置以尿素为唯一氮源的培养基,能够在这个培养基上生长的细菌就是能分解尿素的细菌。
二、操作步骤:(1)土壤取样①土壤要求:酸碱度接近中性且潮湿。
②取样部位:距地表约3~8 cm的土壤层。
(2)样品的稀释测定土壤中细菌的数量,一般选用1×104、1×105和1×106倍稀释的稀释液进行平板培养,当第一次做这个实验时可以将稀释的范围放宽一点。
(3)微生物的培养与观察①培养:根据不同微生物的需要,控制适宜的培养温度和培养时间。
细菌一般在30~37 ℃的温度下培养1~2 d。
②观察a.观察方法:每隔24 h统计一次菌落数目,选取菌落数目稳定时的记录作为结果。
b.记录菌落的特征:包括菌落的形状、大小和颜色等。
2、灭菌培养基:高压蒸汽灭菌法3、培养皿灭菌:干热灭菌法三、操作提示(1)无菌操作①取土样的用具在使用前都需要灭菌。
②实验操作均应在酒精灯火焰旁进行。
(2)做好标记:本实验使用的平板和试管较多,为避免混淆,最好在使用前做好标记。
例如,在标记培养皿时应该注明组别、培养日期和平板上培养样品的稀释度等。
(3)制定计划:对于耗时较长的生物实验,需要事先规划时间,以便提高实验效率,在操作时有条不紊。
土壤中分解尿素的细菌的分离与计数操作中需注意的问题(1)为了保证结果准确,一般选择菌落数在30~300的平板进行计数。
(2)恰当的稀释度是成功统计菌落数目的关键。
(3)为增强实验说服力与准确性,设计实验时,需要涂布至少三个平板作为重复组,目的是排除实验中偶然因素对实验结果的影响。
(4)分析实验结果时,要考虑重复组结果是否接近,如果相差太大,意味着操作有误,需重新实验。
(5)为防止培养时间不足导致菌落遗漏,在菌落计数时,每隔24 h统计一次菌落数目,选取菌落数目稳定时的记录作为结果。
土壤中分解尿素的细菌的分离与计数一、教学目标:1.能按照科学探究的要求,应用稀释涂布平板法和微生物数量测定的方法,设计从土壤中分离分解尿素的细菌并进行计数的方案。
2.依据设计的方案,运用无菌操作技术和微生物分离、培养的方法初步分离出目标菌。
3.尝试解决生产、生活中与微生物选择培养、计数等有关的实际问题。
二、教学重难点:教学重点:实验设计方案的设计与修正,正确进行实验操作教学难点:设计实验方案。
三、教学过程:提出问题(实验目的):(1)从土壤中分离出能够分解尿素的细菌。
(2)统计每克土壤样品中究竟含有多少这样的细菌。
基础知识(实验原理):绝大多数微生物都能利用葡萄糖,但是只有能合成脲酶的微生物才能分解尿素,利用以尿素作为唯一氮源的选择培养基,可以从土壤中分离出分解尿素的细菌。
选择培养基配方: 组分 含量KH 2PO 41.4g Na 2HPO 42.1gMgSO 4·7H 2O0.2g葡萄糖10.0g 尿素1.0g 琼脂 15.0gH 2O定容至1000mL 实验设计:请同学们阅读教材19页资料,思考有关问题,小组合作进行实验设计,写出详细的实验方案,交流修正。
实验步骤:按照方案,选择合适的实验材料,进行实验。
(一)、土壤取样细菌适宜在酸碱度接近中性的潮湿土壤中生长,绝大多数分布在距地表3~8cm 的土壤层。
因此,取样时一般要铲去表层土。
将样品装入纸袋。
注意事项:取土样时用的铁铲和取样袋在使用前都需要灭菌。
操作完成后,一定要洗手。
(二)、制备培养基用牛肉膏蛋白胨培养基作为对照组,用以尿素为唯一氮源的培养基做实验组,用来判断选择培养基是否具有选择作用。
(三)、样品的稀释与涂布平板(稀释涂布平板法)简要回顾操作梯度稀释:在酒精灯火焰旁称取10g土壤,放入盛有90mL无菌水的锥形瓶中,振荡使土壤与水充分混合,将细菌分散,制成101倍土壤稀释液。
用1支1mL无菌吸管从中吸取1mL土壤悬液注入盛有9mL无菌水的试管中,吹吸三次,充分混匀,制成102倍的土壤稀释液。
土壤中分解尿素的细菌的分离与计数一、研究思路1.筛选菌株(1)实验室中微生物筛选的原理:人为提供有利于目的菌株生长的条件(包括营养、温度、pH 等),同时抑制或阻止其他微生物的生长。
(2)选择培养基:在微生物学中,将允许特定种类的微生物生长,同时抑制或阻止其他种类微生物生长的培养基,称做选择培养基。
2.统计菌落数目(1)活菌计数法:常用稀释涂布平板法。
①原理:当样品的稀释度足够高时,培养基表面生长的一个菌落,来源于样品稀释液中的一个活菌。
通过统计平板上的菌落数,就能推测出样品中大约含有多少活菌。
②计算公式:每克样品中的菌株数=(C ÷V )×M 。
C :代表某一稀释度下平板上生长的平均菌落数。
V :代表涂布平板时所用的稀释液的体积(mL)。
M :代表稀释倍数。
③统计方法:为了保证结果准确,一般设置3~5个平板,选择菌落数在30~300的平板进行计数,并取其平均值。
.1.实验室中微生物筛选的原理:人为提供有利于目的菌株生长的条件(包括营养、温度、pH 等)同时抑制或阻止其他微生物的生长。
2.在微生物学中,将允许特定种类的微生物生长,同时抑制或阻止其他种类微生物生长的培养基,称做选择培养基。
3.测定微生物数量的常用方法有活菌计数法和显微镜直接计数法。
稀释涂布平板法常用来统计活菌的数目,但统计结果往往比活菌的实际数目低。
4.只有能合成脲酶的微生物才能分解尿素,因此可用尿素作为唯一氮源的选择培养基分离能分解尿素的细菌。
5.鉴定分解尿素细菌的方法是在以尿素为唯一氮源的培养基中加入酚红指示剂,依据是否变红进行判断。
(2)显微镜直接计数法:在显微镜下直接观察和计数微生物的数量。
3.设置对照(1)对照实验:指除了被测试的条件外,其他条件都相同的实验。
(2)主要目的:排除实验组中非测试因素对实验结果的影响,提高实验结果的可信度。
二、实验设计1.土壤取样从富含有机质、酸碱度接近中性且潮湿的土壤取样。
土壤中分解尿素的细菌的分离与计数在我们生活的地球上,土壤是一个极其复杂而又充满生机的生态系统。
在这个生态系统中,存在着各种各样的微生物,它们在物质循环和能量流动中发挥着至关重要的作用。
其中,分解尿素的细菌就是一类非常特殊且具有重要功能的微生物。
尿素是一种常见的含氮化合物,广泛应用于农业生产中作为氮肥。
然而,植物并不能直接吸收和利用尿素,需要经过分解尿素的细菌将其转化为氨等植物能够吸收的形式。
因此,研究土壤中分解尿素的细菌对于提高氮肥的利用率、减少环境污染以及深入了解土壤生态系统的功能都具有重要意义。
要分离和计数土壤中分解尿素的细菌,首先需要采集合适的土壤样本。
我们通常会选择那些长期施用尿素肥料的农田、花园或者草地的土壤。
在采样时,需要使用无菌的工具,如无菌铲或者无菌勺,从不同的地点和深度采集土壤,以确保样本的代表性和多样性。
将采集到的土壤放入无菌的塑料袋中,并尽快带回实验室进行处理。
回到实验室后,第一步是制备培养基。
用于分离分解尿素的细菌的培养基通常是选择培养基,其中含有尿素作为唯一的氮源。
除此之外,还需要添加碳源(如葡萄糖)、无机盐、生长因子等营养物质,以及琼脂作为凝固剂。
在制备培养基的过程中,要严格遵守无菌操作,防止杂菌的污染。
接下来,将土壤样本进行稀释。
这是一个关键的步骤,目的是将土壤中的微生物分散开来,以便能够在培养基上形成单个的菌落。
我们可以使用无菌水对土壤样本进行一系列的梯度稀释,比如 10 倍、100 倍、1000 倍等。
稀释的程度要根据土壤中微生物的数量和实验的要求来确定。
然后,将稀释后的土壤溶液涂布在制备好的培养基上。
使用无菌的涂布棒,将溶液均匀地涂布在培养基的表面。
涂布完成后,将培养基倒置放入恒温培养箱中进行培养。
培养的温度和时间要根据所分离的细菌的特性来确定,一般来说,温度在 30℃至 37℃之间,培养时间为2 至 3 天。
在培养的过程中,分解尿素的细菌会在培养基上生长并形成菌落。